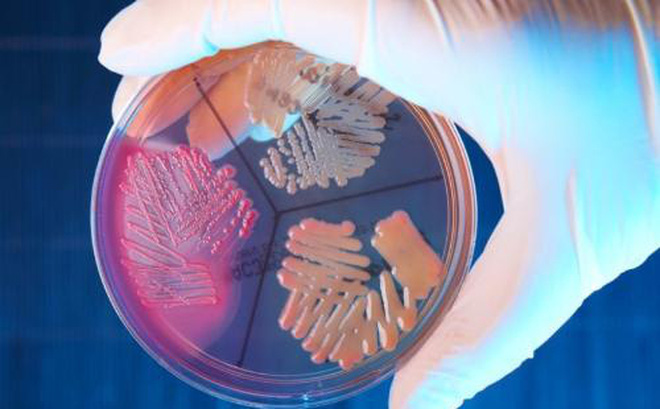
Thuốc Ery-Tab l&agrave; kh&aacute;ng sinh chống lại c&aacute;c vi khuẩn th&ocirc;ng thường

Công dụng của thuốc Ery-Tab
Ery-Tab là một loại thuốc viên nén có tính năng giải phóng chậm với hàm lượng 250 mg, 333 mg hoặc 500 mg erythromycin làm thành phần cơ sở. Hàm lượng Erythromycin thuộc về một nhóm thuốc gọi là kháng sinh macrolide. Kháng sinh Macrolide làm chậm sự phát triển của vi khuẩn hoặc đôi khi tiêu diệt các loại vi khuẩn nhạy cảm trong cơ thể bằng cách giảm sản xuất các protein quan trọng cần thiết cho vi khuẩn để tồn tại.
Thuốc Ery-Tab là kháng sinh chống lại các vi khuẩn thông thường
Thuốc kháng sinh này dùng điều trị hoặc ngăn ngừa nhiễm trùng do vi khuẩn. Nó sẽ không hoạt động đối với các bệnh nhiễm trùng do virus (như cảm lạnh thông thường, cúm). Sử dụng không cần thiết hoặc lạm dụng bất kỳ loại kháng sinh nào có thể dẫn đến giảm hiệu quả của nó.
Ery-Tab được sử dụng để điều trị hoặc ngăn ngừa những loại nhiễm trùng khác nhau do vi khuẩn gây ra, thuốc Ery cũng có thể được dùng cho mục đích khác không được liệt kê trong hướng dẫn thuốc này.
Cách sử dụng thuốc Ery-Tab
Dùng thuốc theo chỉ dẫn của bác sĩ. Thuốc này được hấp thụ tốt nhất khi bụng đói. Nếu có triệu chứng buồn nôn xảy ra, bạn có thể dùng nó kèm với thức ăn hoặc sữa. Nuốt cả viên thuốc. Đừng nghiền nát, nhai hoặc bẻ vỡ nó.
Liều lượng và thời gian điều trị với Ery-Tab dựa trên tình trạng y tế của bạn và sự đáp ứng với điều trị. Ở trẻ em, liều lượng cũng dựa trên tuổi và cân nặng. Thông thường sẽ uống từ 2 – 4 liều một ngày. Để có hiệu quả tốt nhất, hãy dùng thuốc kháng sinh này trong khoảng thời gian cách đều nhau.
Nếu bạn đang sử dụng thuốc này để điều trị nhiễm trùng, hãy tiếp tục dùng thuốc này cho đến khi hết lượng thuốc theo quy định, ngay cả khi các triệu chứng biến mất sau vài ngày. Ngừng thuốc quá sớm có thể dẫn đến sự quay trở lại của nhiễm trùng. Hãy cho các bác sĩ biết nếu tình trạng của bạn vẫn còn hoặc xấu đi.
Tác dụng phụ của Ery-Tab
Đa số trường hợp sử dụng thuốc này không có tác dụng phụ nghiêm trọng. Các tác dụng phụ thường thấy có thể là: buồn nôn, nôn, tiêu chảy, đau dạ dày, chuột rút và chán ăn.Nhiều người không có tác dụng phụ hoặc tác dụng phụ rất nhỏ, ít nghiêm trọng.
Dùng thuốc này kèm với thức ăn có thể làm giảm các triệu chứng này. Nếu bất kỳ tác dụng nào trong số này vẫn còn hoặc xấu đi, hãy báo cho bác sĩ hoặc dược sĩ của bạn kịp thời.
Cần đi khám ngay lập tức nếu bạn có bất kỳ tác dụng phụ nghiêm trọng nào, bao gồm: các dấu hiệu của bệnh gan (như buồn nôn/nôn kéo dài, mắt vàng hoặc da, nước tiểu sẫm màu, đau bụng/đau bụng nghiêm trọng), mệt mỏi bất thường, yếu cơ, nói chậm, mờ mắt, sụp mí mắt, giảm thính lực.

Ery-Tab không gây ra các tác dụng phụ quá nghiêm trọng
Nhận trợ giúp y tế ngay lập tức nếu bạn có bất kỳ tác dụng phụ rất nghiêm trọng, bao gồm: chóng mặt nghiêm trọng, bị tình trạng bị ngất xỉu, nhịp tim đập nhanh hoặc đập không đều.
Sử dụng thuốc này trong thời gian dài hoặc lặp đi lặp lại có thể dẫn đến bệnh tưa miệng hoặc nhiễm trùng nấm men mới. Liên hệ với bác sĩ của bạn nếu bạn nhận thấy các mảng trắng trong miệng, thay đổi dịch tiết âm đạo hoặc các triệu chứng mới khác.
Chống chỉ định và lưu ý
Bệnh nhân chú ý là không sử dụng Ery-Tab cho các trường hợp sau:
- Bệnh nhân bị khả năng dị ứng với các thành phần của Ery-Tab, hoặc với các kháng sinh macrolide khác (như azithromycin, clarithromycin).
- Bệnh nhân bị hoặc có tiền sử bệnh gan, thận, nhược cơ cần thận trọng trước khi sử dụng hoặc tuyệt đối không sử dụng.
-
Một số loại thuốc có thể gây ra một số tác dụng phụ không mong muốn hoặc là nguy hiểm khi sử dụng với Ery, trước khi sử dụng bạn hãy nói với bác sĩ nếu bị bệnh gan, rối loạn nhịp tim, nhược cơ, tiền sử hội chứng Long QT hoặc nồng độ kali hoặc magie trong máu bị thấp.
-
Ery có thể gây tiêu chảy hoặc dấu hiệu của nhiễm trùng mới, nếu bạn bị tiêu chảy nước hoặc có máu thì hãy ngừng dùng Ery và gọi cho bác sĩ để được tư vấn.
- Nếu bạn đang ăn chế độ ít muối hoặc không có muối hãy nói với bác sĩ để được tư vấn kỹ càng nhất vì những bệnh nhân kiêng ăn muối nhiều không nên dùng thuốc này sẽ có phản ứng phụ.
Erythromycin có thể khiến vắc-xin vi khuẩn sống (như vắc-xin thương hàn) không hoạt động tốt. Không được tiêm chủng trong khi sử dụng thuốc này trừ khi bác sĩ khuyến cáo bạn.
Một số sản phẩm erythromycin có thể chứa natri. Hỏi bác sĩ hoặc dược sĩ của bạn để biết thêm thông tin nếu bạn đang ăn kiêng hạn chế muối hoặc nếu bạn có một tình trạng bệnh như suy tim sung huyết có thể trở nên tồi tệ hơn khi tăng lượng muối.
Phụ nữ có thai và đang cho con bú cần hỏi kỹ hướng dẫn của bác sĩ trước khi sử dụng Ery-Tab, chưa có khuyến cáo khuyên dùng cho phụ nữ đang cho con bú.
Bạn không nên nghiền nát thuốc hoặc nhai thuốc mà nên nuốt cả viên để có tác dụng tốt nhất. Nếu bỏ lỡ một liều hãy uống sớm nhất có thể và không được uống gấp đôi liều để bù.
Trên đây là một số chia sẻ về thuốc kháng sinh Ery-Tab. Lưu ý rằng các thông tin trong bài viết chỉ mang tính chất tham khảo. Nếu bạn muốn dùng thuốc thì tốt nhất nên đến các cơ sở y tế để được tư vấn và hướng dẫn cụ thể, chính xác.
Nguồn: Cao đẳng Y dược Sài Gòn tổng hợp
096.152.9898 - 093.851.9898
Thuốc Alavert có tác dụng trong điều trị bệnh gì?
Công dụng của thuốc Queisser và những lưu ý khi dùng thuốc
Lưu ý điều gì khi sử dụng thuốc Yspbio Tase trong điều trị bệnh?
Cách sử dụng thuốc Yunpro để bổ sung vi khuẩn có lợi cho đường ruột
Thuốc Yasmin cách sử dụng như thế nào? Có lưu ý gì trong quá trình dùng không?
Tìm hiểu thông tin về thuốc S prenatal
Trường Cao đẳng Y Dược Sài Gòn trao tặng bằng khen cho các tập thể, cá nhân có thành tích xuất sắc trong công tác phòng, chống dịch Covid – 19



– Cơ sở 1:
Email:
Điện thoại: 0287.1060.222 – 096.152.9898 – 093.851.9898




